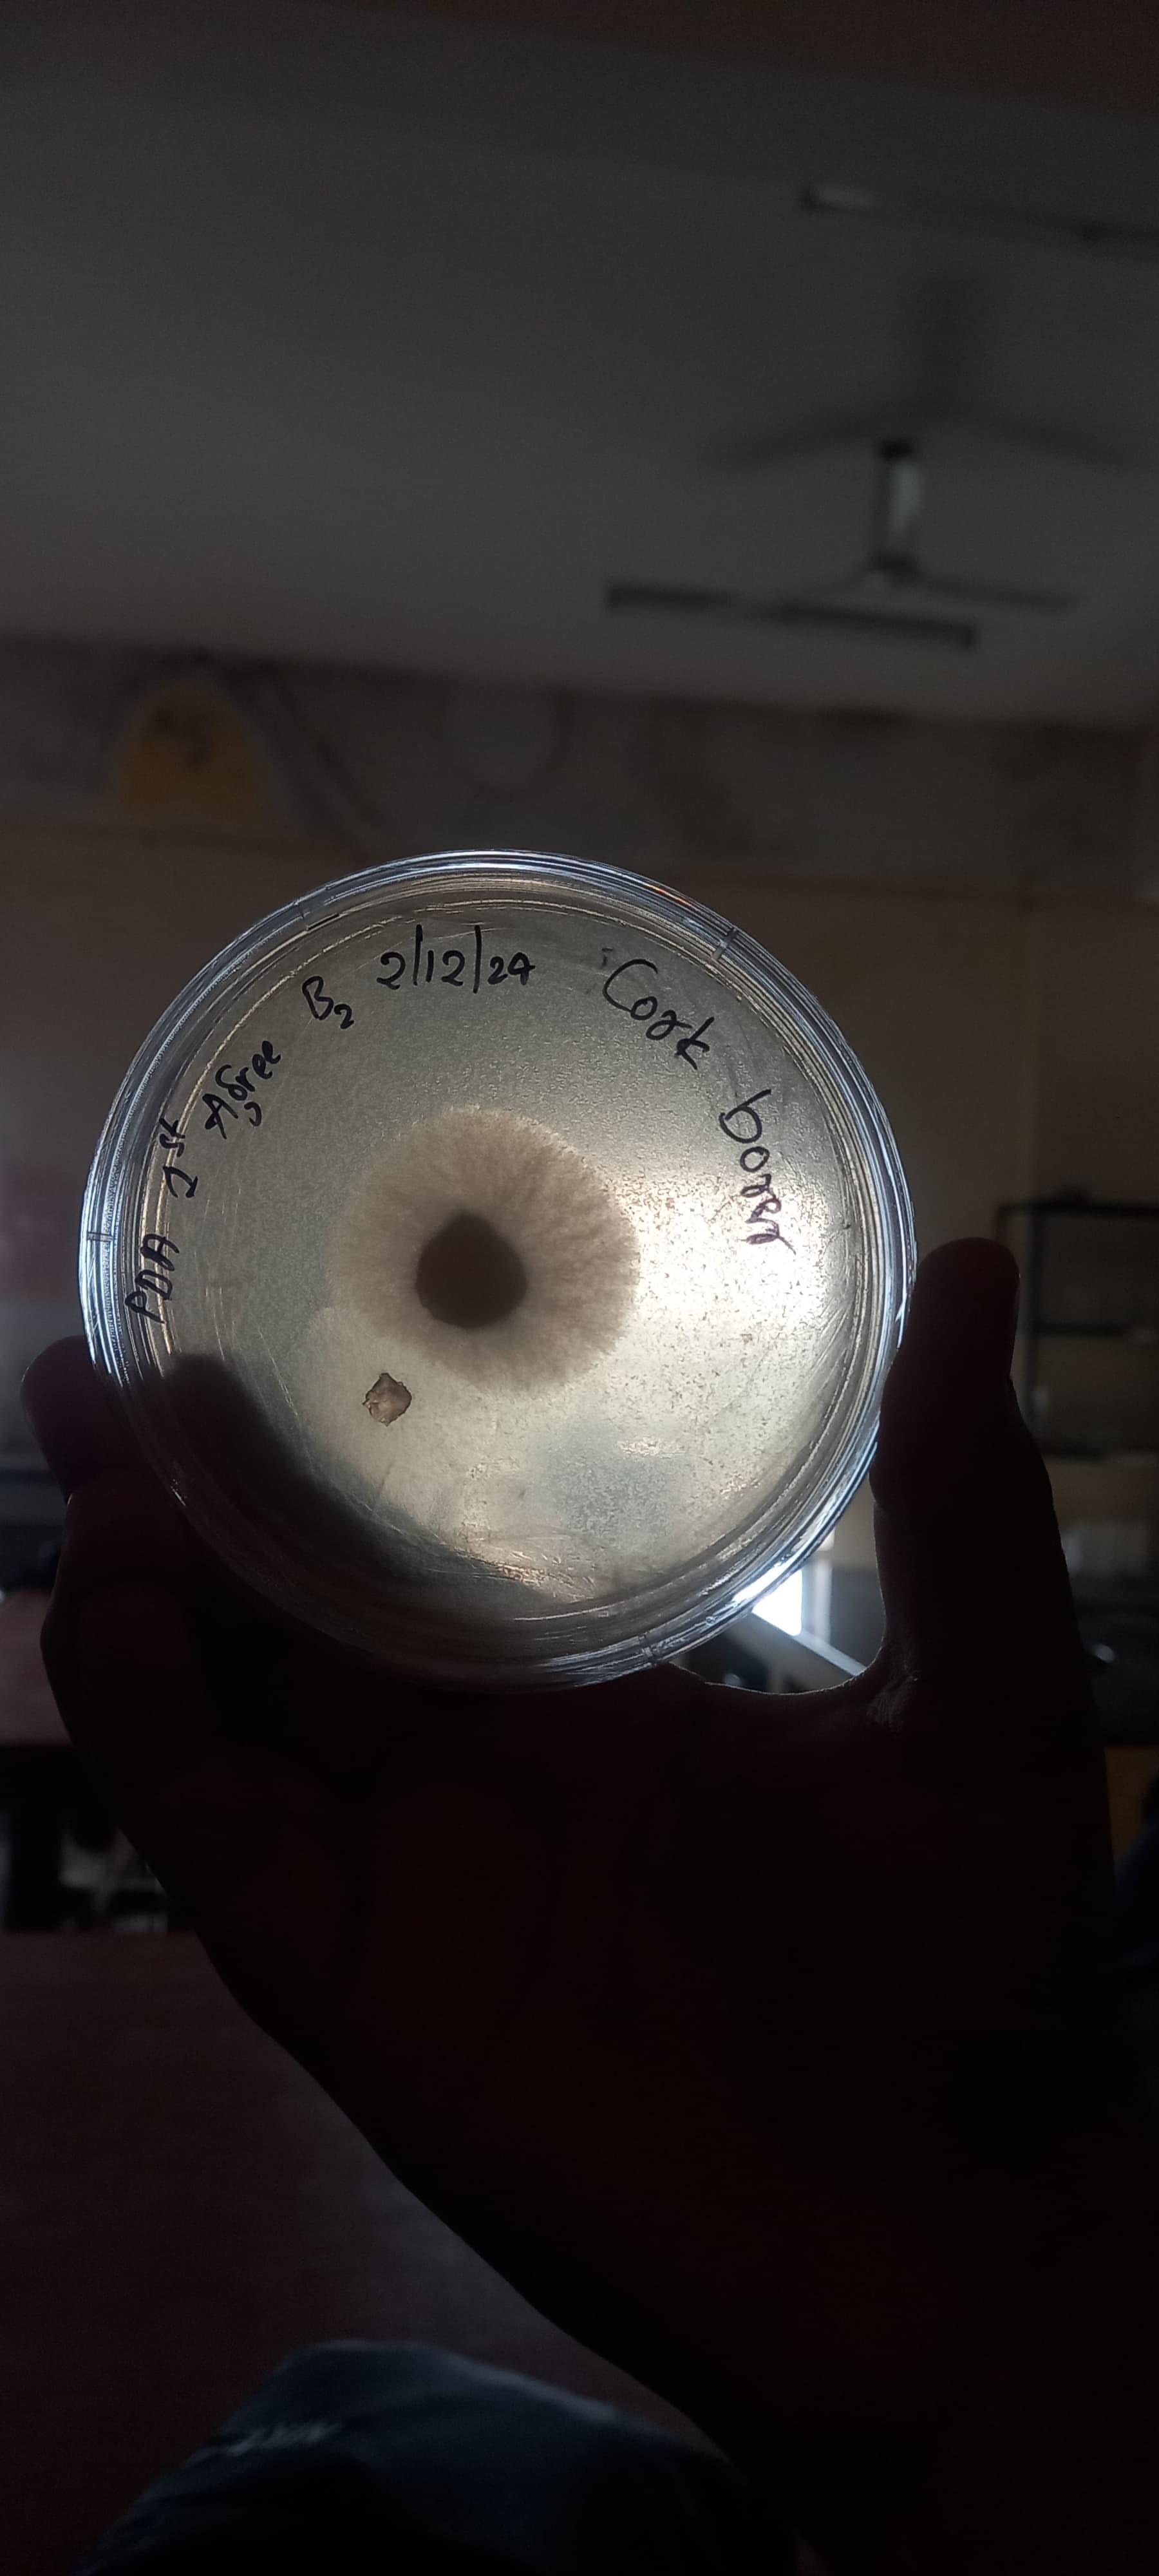

College of Agriculture in Hassan, Karnataka was set up with an aim to enhance agricultural education by imparting education, research and training in the field of Agriculture and food science technology. It was started to help the rural society in particular by developing such manpower, which can be trained in this field and genuine farming methods to enhance the agricultural production. College of Agriculture is offering Bachelor degree programmers in Agriculture, Agriculture Biotechnology and Food Science technology. This institution provides its students a hands-on-experience on agricultural fields and emphasize on experimental learning.
College of Agriculture Facts and Figures
|
Founded In |
1996 |
|
Founder |
University of Agricultural Science and inaugurated By Shri.H.D.Devegowda. |
|
Accredited by |
Indian Council of Agricultural Research |
|
Campus |
It covers about 185 acres of land of Hassan District in Karnataka. |
|
On Campus Strength |
600 ( approx. 300 boys and 299 girls and 2 students from abroad) |
|
How to Travel |
|
Why to Join College of Agriculture?
1. Advanced learning Programmes:
The institute is running advanced learning programmes in order to enhance rural agricultural education. Its degree programmes are especially designed to promote agricultural research and field education. The course curriculum is appropriate in consideration to current scenario of nation’s state of Agriculture.
2. Magnificent infrastructural facilities:
The College boasts of its modern and best infrastructural facilities which comprises of spacious and ventilated Class-rooms, Advanced laboratories, well maintained Seminar Halls, video surveillance system, image projector etc.
3. Advanced Experimental teaching programmes:
The College is proud of its highly qualified faculties who believe in grass-root teaching methods and advanced experimental approach. They motivate the students to understand the subject in perspective to country’s agro-climatic conditions, rural modus-operandi and thus come up with evolutionary ideas which can transform the face of Agriculture by leaps and bounds.
4. Guest Lectures from eminent personalities-
Many honorable and known personalities, businessmen and ministers are often invited to share their experiences and spread knowledge on the growth, advancement and essence of Agriculture.

![University of Agricultural Sciences - [UAS]](https://image-static.collegedunia.com/public/college_data/images/appImage/25628_UAS_APP.jpg?h=111.44&w=263&mode=stretch)
![University of Agricultural Sciences - [UAS]](https://image-static.collegedunia.com/public/college_data/images/logos/1438171323university of agriculture.jpg?h=42.55&w=42.98&mode=stretch)
.jpeg?h=78&w=78&mode=stretch)
.png?h=78&w=78&mode=stretch)





















![University of Agricultural Sciences - [UAS]](https://image-static.collegedunia.com/public/college_data/images/logos/1438171323university of agriculture.jpg?h=72&w=72&mode=stretch)
.jpeg?h=72&w=72&mode=stretch)
.png?h=72&w=72&mode=stretch)


















Comments
Found 4 Comments
College of Agriculture offers three under graduation degree programs. It offers a B.Sc. in Agriculture for a duration of three years. B.Tech. is offered with two specializations- Biotechnology and Food Science & Technology for a duration of four years. To be eligible for admission to any of the above-mentioned programs, the candidates must possess a 10+2 qualification. Admission to the same will be granted on the basis of the candidate’s performance in the Entrance exam.
You can contact the College of Agriculture Hassan at 080-23330153
Given below are the details of College of Agriculture Hassan: